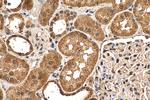
CHERP Antibody in Immunohistochemistry (Paraffin) (IHC (P))

Search
Proteintech
CHERP Polyclonal Antibody
{{$productOrderCtrl.translations['antibody.pdp.commerceCard.promotion.promotions']}}
{{$productOrderCtrl.translations['antibody.pdp.commerceCard.promotion.viewpromo']}}
{{$productOrderCtrl.translations['antibody.pdp.commerceCard.promotion.promocode']}}: {{promo.promoCode}} {{promo.promoTitle}} {{promo.promoDescription}}. {{$productOrderCtrl.translations['antibody.pdp.commerceCard.promotion.learnmore']}}
产品信息
25389-1-AP
种属反应
宿主/亚型
分类
类型
抗原
偶联物
形式
浓度
规格
纯化类型
保存液
内含物
保存条件
运输条件
产品详细信息
Immunogen sequence: EFYSYYKCK LALEQQQLIC KQQTPELEPA ATMPPLPQPP LAPAAPIPPA QGAPSMDELI QQSQWNLQQQ EQHLLALRQE QVTAAVAHAV EQQMQKLLEE TQLDMNEFDN LLQPIIDTCT KDAISAGKNW MFSNAKSPPH CELMAGHLRN RITADGAHFE LRLHLIYLIN DVLHHCQRKQ ARELLAALQK VVVPIYCTSF LAVEEDKQQK IARLLQLWEK NGYFDDSIIQ QLQSPALGLG QYQATLINEY SSVVQPVQLA FQQQIQTLKT QHEEFVTSLA QQQQQQQQQQ QQLQMPQMEA EVKATPPPPA PPPAPAPAPA IPPTTQPDDS KPP (19-350 aa encoded by BC021294)
靶标信息
CHERP is involved in calcium homeostasis, growth and proliferation.
仅用于科研。不用于诊断过程。未经明确授权不得转售。
篇参考文献 (0)
生物信息学
蛋白别名: Calcium homeostasis endoplasmic reticulum protein; cherp; DAN26; ERPROT 213-21; ERPROT213-21; protein with polyglutamine repeat; spliceosome associated factor; SCAF6; SR-related CTD associated factor 6; SR-related CTD-associated factor 6; unnamed protein product
基因别名: 5730408I11Rik; CHERP; D8Wsu96e; DAN16; DAN26; SCAF6; SRA1
UniProt ID: (Human) Q8IWX8, (Mouse) Q8CGZ0
Entrez Gene ID: (Human) 10523, (Mouse) 27967